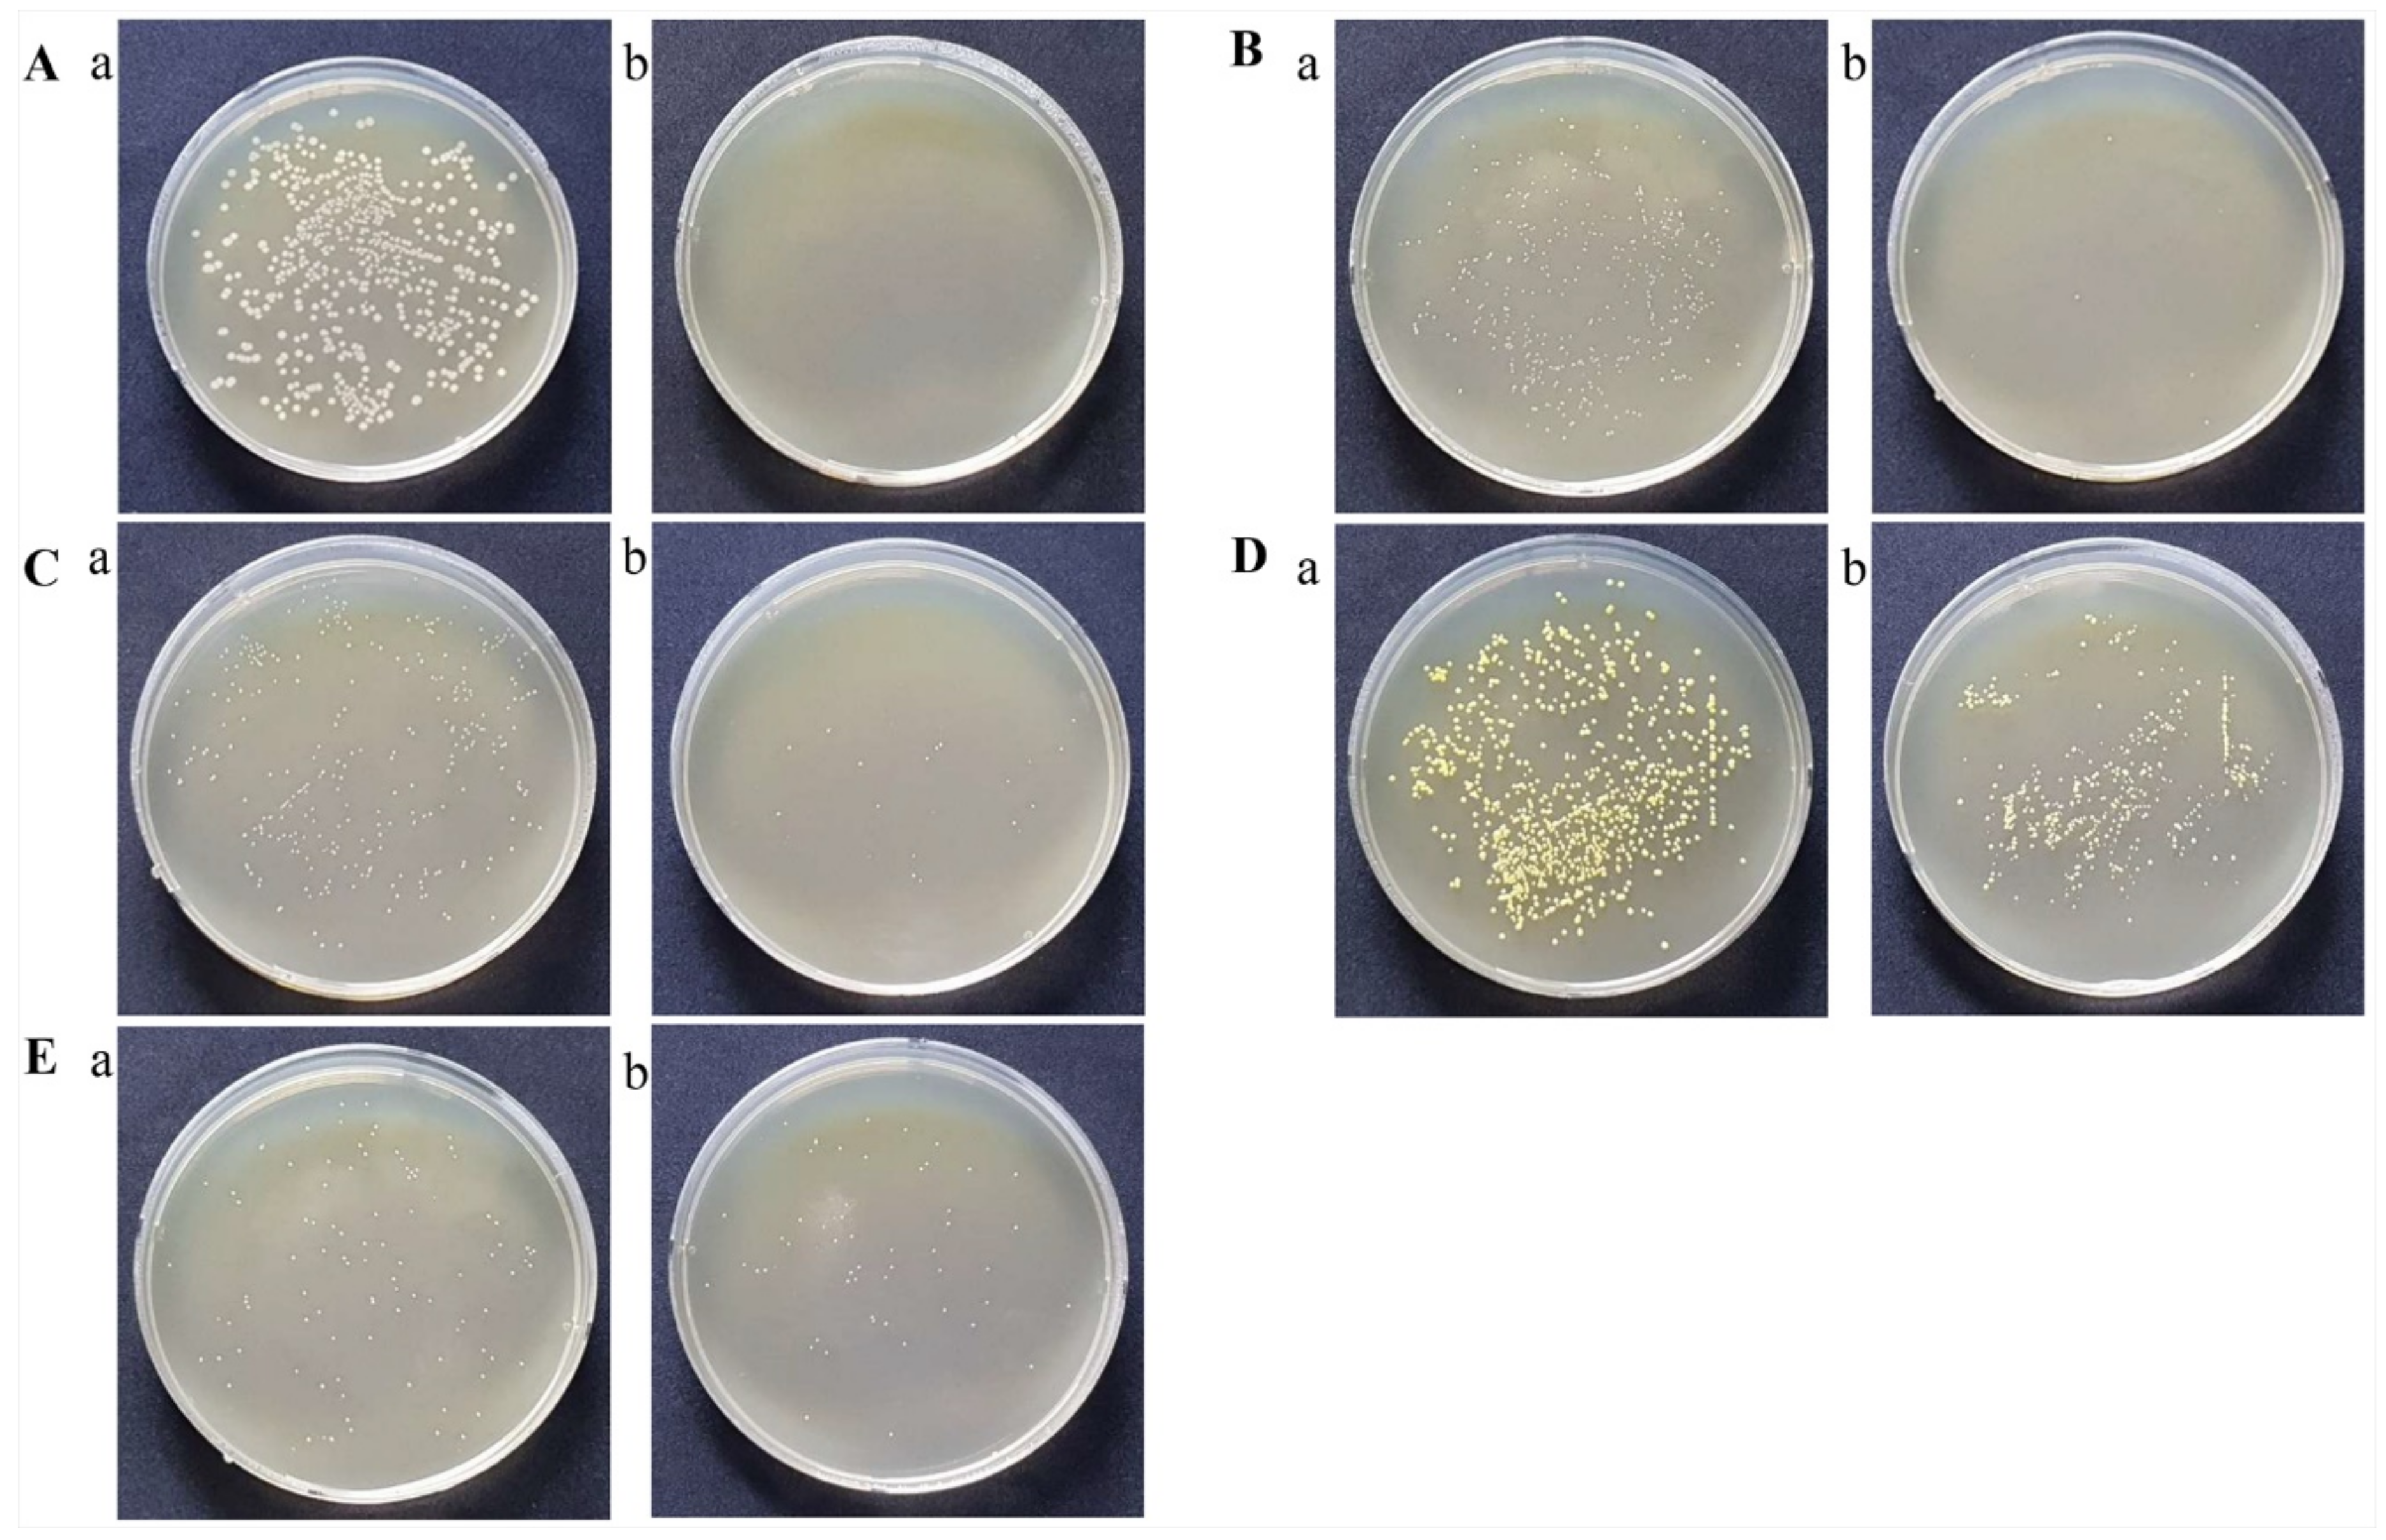
Processes 08 01481 g001

Bactericidal and Virucidal Efficacies and Safety of Puriton®
Abstract
1. Introduction
2. Materials and Methods
2.1. Puriton® Components
2.2. Bacterial Culture, Culturable Conditions, Virus Culture, and Cytopathic Effect (CPE) Examination
2.3. Animal Experiment
2.4. Macroscopic, Physiological, and Histopathological Evaluations
2.5. Statistical Analysis
3. Results
3.1. Puriton® Controlled the Colonies of Nine Pathogenic Bacteria
3.2. Puriton® Suppressed the Cytopathic Effects of Zika Virus and H5N1 Virus
3.3. Puriton® Oral Administration Was Safe at under 800 μL
4. Discussion
5. Conclusions
Supplementary Materials
Author Contributions
Funding
Conflicts of Interest
References
- World Health Organization. The Top 10 Causes of Death. Available online: https://www.who.int/en/news-room/fact-sheets/detail/the-top-10-causes-of-death (accessed on 16 November 2020).
- Global Diarrhea Burden. Available online: https://www.cdc.gov/healthywater/global/diarrhea-burden.html (accessed on 16 November 2020).
- Omer, M.K.; Alvarez-Ordonez, A.; Prieto, M.; Skjerve, E.; Asehun, T.; Alvseike, O.A. A systematic review of bacterial foodborne outbreaks related to red meat and meat products. Foodborne Pathog. Dis. 2018, 15, 598–611. [Google Scholar] [CrossRef] [PubMed]
- Yang, S.C.; Lin, C.H.; Aljuffali, I.A.; Fang, J.Y. Current pathogenic Escherichia coli foodborne outbreak cases and therapy development. Arch. Microbiol. 2017, 199, 811–825. [Google Scholar] [CrossRef] [PubMed]
- Gellatly, S.L.; Hancock, R.E. Pseudomonas aeruginosa: New insights into pathogenesis and host defenses. Path. Dis. 2013, 67, 159–173. [Google Scholar] [CrossRef] [PubMed]
- Bizet, J.; Bizet, C. Strains of Alacligenes faecalis from clinical material. J. Infect. 1997, 35, 167–169. [Google Scholar] [CrossRef]
- Filipe, M.; Reimer, A.; Matuschek, E.; Paul, M.; Pelkonen, T.; Riesbeck, K. Fluoroquinolone-resistant Alacligenes faecalis related to chronic suppurative otitis media, Angola. Emerg. Infect. Dis. 2017, 23, 1740–1742. [Google Scholar] [CrossRef]
- Tena, D.; Fernandez, C.; Lago, M.R. Alacligenes faecalis: An unusual cause of skin and soft tissue infection. Jpn. J. Infect. Dis. 2015, 68, 128–130. [Google Scholar] [CrossRef]
- Schenck, L.P.; Surette, M.G.; Bowdish, D.M. Composition and immunological significance of the upper respiratory tract microbiota. FEBS Lett. 2016, 590, 3705–3720. [Google Scholar] [CrossRef]
- Wollina, U. Microbiome in atopic dermatitis. Clin. Cosmet. Investig. Dermatol. 2017, 10, 51–56. [Google Scholar] [CrossRef]
- Tong, S.Y.; Davis, J.S.; Eichenberger, E.; Holland, T.L.; Fowler, V.G. Staphylococcus aureus infections: Epidermiology, pathophysiology, clinical manifestations, and management. Clin. Microbiol. Rev. 2015, 28, 603–661. [Google Scholar] [CrossRef]
- Rasmussen, R.V.; Fowler, V.G.; Skov, R.; Bruun, N.E. Future challenges and treatment of Staphylococcus aureus bacteremia with emphasis on MRSA. Future Microbiol. 2011, 6, 43–56. [Google Scholar] [CrossRef]
- Murray, B.E. The life and times of the Enterococcus. Clin. Microbiol. Rev. 1990, 3, 46–65. [Google Scholar] [CrossRef] [PubMed]
- Hidron, A.I.; Edwards, J.R.; Patel, J.; Horan, T.C.; Sievert, D.M.; Pollock, D.A.; Fridkin, S.K. NHSN annual update: Antimicrobial-resistant pathogens associated with healthcare-associated infections: Annual summary of data reported to the National Healthcare Safety Network at the Centers for Disease Control and Prevention, 2006–2007. Infect. Control. Hosp. Epidermiol. 2008, 29, 996–1011. [Google Scholar] [CrossRef] [PubMed]
- Albertson, D.; Natsios, G.A.; Gleckman, R. Septic shock with Micrococcus luteus. Arch. Intern. Med. 1978, 138, 487–488. [Google Scholar] [CrossRef] [PubMed]
- Reyrat, J.M.; Kahn, D. Mycrobacterium smegmatis: An absurd model for tuberculosis? Trends Microbiol. 2001, 19, 472–473. [Google Scholar] [CrossRef]
- Apetroaie-Constantin, C.; Mikkola, R.; Andersson, M.A.; Teplova, V.; Suominen, I.; Johansson, T. Salkinoja-salonen M: Bacillus subtilis and B. mojavensis strains connected to food poisoning produced the heat stable toxin amylosin. J. Appl. Microbiol. 2009, 106, 1976–1985. [Google Scholar] [CrossRef] [PubMed]
- World Health Organization: Diabetes. Diabetes Fact Sheet: 30 October 2018. Available online: https://communitymedicine4all.com/2018/11/05/who-updates-fact-sheet-on-diabetes (accessed on 16 November 2020).
- American Diabetes Association. Diagnosis and classification of diabetes mellitus. Diabetes Care 2009, 32 (Suppl. 1), S62–S97. [Google Scholar] [CrossRef]
- Gomes, C.S.F. Healing and edible clays: A review of basic concepts, benefits and risks. Envrion. Geochem. Health. 2018, 40, 1739–1765. [Google Scholar] [CrossRef]
- Parisi, F.; Lazzara, G.; Merli, M.; Milioto, S.; Princivalle, F.; Sciascia, L. Simultaneous removal and recovery of metal ions and dyes from wastewater through montmorillonite clay mineral. Nanomaterials 2019, 9, 1699. [Google Scholar] [CrossRef]
- Shiraishi, H.; Fujino, M.; Shirakawa, N.; Ishida, N.; Funato, H.; Hirata, A.; Abe, N.; Iizuka, M.; Jobu, K.; Yokota, J.; et al. Effect of minerals on intestinal IgA production using deep sea water drinks. Biol. Pharm. Bull. 2017, 40, 1700–1705. [Google Scholar] [CrossRef]
- Hirabayashi, T.; Yamashita, M.; Wada, N.; Takenoya, F.; Ikeda, H.; Kamei, J.; Ryushi, T.; Yamamoto, N.; Shioda, S. Analgesic effect of mineral cream containing natural spa minerals for use on the skin. Biomed. Res. Tokyo 2018, 39, 215–222. [Google Scholar] [CrossRef]
- Wang, H.; Liu, Z.; Huang, M.; Wang, S.; Cui, D.; Dong, S.; Li, S.; Qi, Z.; Liu, Y. Effects of long-term mineral block supplementation on antioxidants, immunity, and health of Tibetan sheep. Biol. Trace Elem. Res. 2016, 172, 326–335. [Google Scholar] [CrossRef] [PubMed]
- Haggett, P.; Gunawardena, K.A. Determination of population thresholds for settlement functions by the Reed-Muench method. Prof. Geogr. 2010, 16, 6–9. [Google Scholar] [CrossRef]
- Lee, J.A.; Jung, B.G.; Kim, T.H.; Kim, Y.M.; Koh, H.B.; Lee, B.J. Improvement of bacterial clearance and relief of clinical signs of Salmonella enterica serovar Typhimurium infection in pigs through upregulation of Th1-specific responses by administration of a combination of two silicate minerals, biotite and bentonite. J. Vet. Med. Sci. 2015, 77, 1087–1094. [Google Scholar] [CrossRef] [PubMed][Green Version]
- Awad, M.E.; Lopez-Galindo, A.; Setti, M.; El-Rahmany, M.M.; Iborra, C.V. Kaolinite in pharmaceutics and biomedicine. Int. J. Pham. 2017, 533, 34–48. [Google Scholar] [CrossRef] [PubMed]
- Qin, C.; Chen, C.; Shang, C.; Xia, K. Fe(3+)-saturated montmorllonite effectively deactivates bacteria in wastewater. Sci. Total Environ. 2018, 622–623, 88–95. [Google Scholar] [CrossRef] [PubMed]
- Jung, B.G.; Lee, J.A.; Lee, B.J. Antiviral effect of dietary germanium biotite supplementation in pigs experimentally infected with porcine reproductive and respiratory syndrome virus. J. Vet. Sci. 2013, 14, 135–141. [Google Scholar] [CrossRef]
- Jung, M.; Shin, M.K.; Jung, Y.K.; Yoo, H.S. Modulation of macrophage activities in proliferation, lysosome, and phagosome by the nonspecific immunostimulatory, mica. PLoS ONE. 2015, 10, e0117838. [Google Scholar] [CrossRef]
- Kaur, J. A comprehensive review on metabolic syndrome. Cardiol. Res. Pract. 2014, 2014, 943162. [Google Scholar] [CrossRef]
- Liu, H.H.; Li, J.J. Aging and dyslipidemia: A review of potential mechanisms. Ageing Res. Rev. 2015, 19, 43–52. [Google Scholar] [CrossRef]
- Telithromycin: Review of adverse effects. Prescrire Int. 2014, 23, 264–266. Available online: https://pubmed.ncbi.nlm.nih.gov/25954793/ (accessed on 16 November 2020).
- Westphal, J.F.; Vetter, D.; Brogard, J.M. Hepatic side-effects of antibiotics. J. Antimicrob. Chemother. 1994, 33, 387–401. [Google Scholar] [CrossRef] [PubMed]
- Ianiro, G.; Tilg, H.; Gasbarrini, A. Antibiotics as deep modulators of gut microbiota: Between good and evil. Gut 2016, 65, 1906–1915. [Google Scholar] [CrossRef] [PubMed]
- Schlegel, P.N.; Chang, T.S.; Marshall, F.F. Antibiotics: Potential hazards to male fertility. Fertil. Steril. 1991, 55, 235–242. [Google Scholar] [CrossRef]

| NO | Micro-Organisms | Before Treatment CFU/mL | At 30 min after Treatment CFU/mL | Inhibition Rate (%) |
|---|---|---|---|---|
| 1 | Alacligenes faecalis ATCC1004 | 21,750,000 | 0 | 100.0 |
| 2 | Escherichia coli KCTC1923 | 317,200 | 0 | 100.0 |
| 3 | Pseudomonas aeruginosa ATCC BAA-1744 | 1,147,200 | 0 | 100.0 |
| 4 | Salmonella typhimrium KCTC1925 | 170,000 | 0 | 100.0 |
| 5 | Staphylococcus aureus KCTC1928 | 173,400 | 700 | 99.9 |
| 6 | Enterococcus faecalis ATCC29212 | 13,700,000 | 40,000 | 97.8 |
| 7 | Micrococcus luteus ATCC9341 | 23,650,000 | 850,000 | 96.4 |
| 8 | Mycrobacterium smegmatis ATCC9341 | 8,400,000 | 90,000 | 93.9 |
| 9 | Bacillus subtilis ATCC6633 | 3,100,000 | 275,000 | 91.9 |
| Contact Time (h) | 90% Puriton® | 50% Puriton® | 70% Puriton® | Water | |
|---|---|---|---|---|---|
| a CCID50 Per 100 μL | 4 | 0.7 ± 0.0 *** | 0.7 ± 0.0 *** | 0.8 ± 0.2 *** | 5.0 ± 0.00 |
| Log reduction value | 4 | >4.3 | >4.3 | 4.2 | n/a |
| a CCID50 Per 100 μL | 18 | b <0.7 *** | 0.7 ± 0.0 *** | b <0.7 *** | 5.2 ± 0.3 |
| Log reduction value | 18 | >4.5 | 4.5 | >4.5 | n/a |
| Contact Time (h) | 90% Puriton® | 50% Puriton® | 70% Puriton® | Water | |
|---|---|---|---|---|---|
| a CCID50Per 100 μL | 4 | b <0.7 *** | 1.9 ± 0.5 *** | b <0.7 *** | 4.5 ± 0.2 |
| Log reduction value | 4 | >3.8 | 2.6 | >3.8 | n/a |
| a CCID50Per 100 μL | 18 | b <0.7 *** | <0.7 *** | b <0.7 *** | 4.1 ± 0.4 |
| Log reduction value | 18 | >3.4 | >3.4 | >3.4 | n/a |
Publisher’s Note: MDPI stays neutral with regard to jurisdictional claims in published maps and institutional affiliations. |
© 2020 by the authors. Licensee MDPI, Basel, Switzerland. This article is an open access article distributed under the terms and conditions of the Creative Commons Attribution (CC BY) license (http://creativecommons.org/licenses/by/4.0/).
Share and Cite
Bok, S.-H.; Kim, M.-H.; Lee, S.-Y.; Bae, C.-S.; Lee, M.-J.; Kim, K.-H.; Park, D.-H. Bactericidal and Virucidal Efficacies and Safety of Puriton®. Processes 2020, 8, 1481. https://doi.org/10.3390/pr8111481
Bok S-H, Kim M-H, Lee S-Y, Bae C-S, Lee M-J, Kim K-H, Park D-H. Bactericidal and Virucidal Efficacies and Safety of Puriton®. Processes. 2020; 8(11):1481. https://doi.org/10.3390/pr8111481
Chicago/Turabian StyleBok, So-Hyeon, Min-Hee Kim, Soon-Young Lee, Chun-Sik Bae, Min-Jae Lee, Kwang-Ho Kim, and Dae-Hun Park. 2020. "Bactericidal and Virucidal Efficacies and Safety of Puriton®" Processes 8, no. 11: 1481. https://doi.org/10.3390/pr8111481
APA StyleBok, S.-H., Kim, M.-H., Lee, S.-Y., Bae, C.-S., Lee, M.-J., Kim, K.-H., & Park, D.-H. (2020). Bactericidal and Virucidal Efficacies and Safety of Puriton®. Processes, 8(11), 1481. https://doi.org/10.3390/pr8111481
